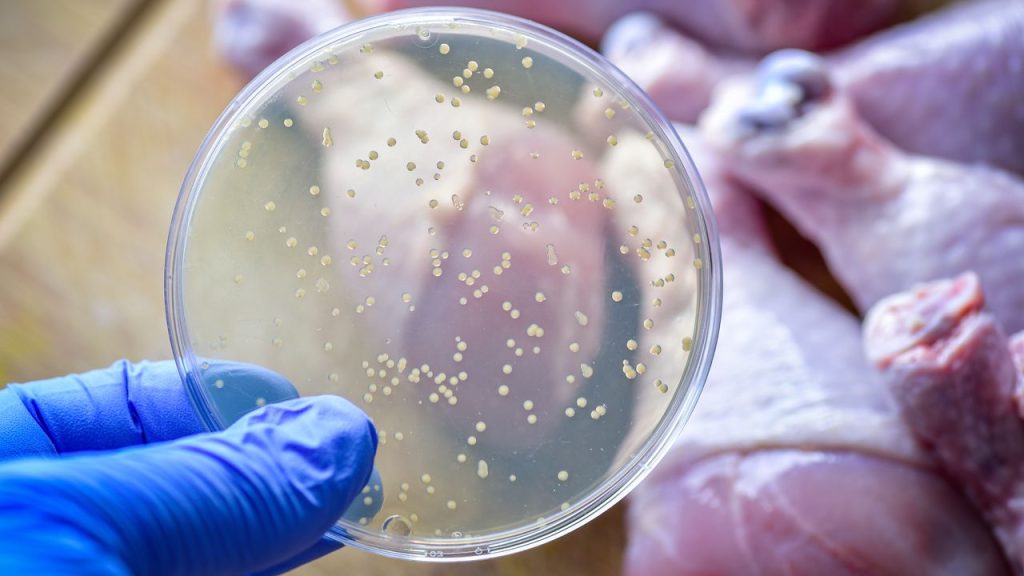

Une crise sanitaire majeure liée aux aliments contaminés
Chaque année, environ 600 millions de personnes à travers le monde tombent victimes de maladies d’origine alimentaire. Parmi les coupables les plus fréquents, on compte l’Escherichia coli et la Salmonella, responsables d’infections graves allant de gastro-entérites à des septicémies potentiellement mortelles. Face à cette menace, l’industrie agroalimentaire utilise massivement des antibiotiques pour prévenir la prolifération bactérienne, ce qui a contribué à faire émerger des superbactéries résistantes aux traitements conventionnels.
La résistance aux antibiotiques est aujourd’hui l’une des principales urgences de santé publique. En Europe, plus de 670 000 infections liées à des bactéries multirésistantes sont recensées chaque année, causant plus de 35 000 décès. Selon certaines estimations, si rien n’est fait, la mortalité due à cette « pandémie silencieuse » pourrait dépasser celle du cancer d’ici 2050.
Des patchs micro-aiguilles remplis de bactériophages
Pour éviter d’alourdir la balance de l’antibiorésistance, des chercheurs de la McMaster University au Canada proposent une solution radicalement différente : des pansements non invasifs, ou « cerotti », chargés de virus bactériophages spécialisés. Ces patchs intègrent une série de micro-aiguilles souples capables de perforer superficiellement la paroi des aliments (peau de fruits, surface de la viande, etc.) pour y injecter directement les virus tueurs de bactéries.
Contrairement aux sprays traditionnels, qui ne s’attaquent qu’à la flore bactérienne en surface, ces pansements micro-aiguilles permettent de délivrer les phages en profondeur, là où les bactéries pathogènes se nichent parfois dans les fibres alimentaires. Ce mode d’administration ciblé maximise l’efficacité tout en restant totalement inoffensif pour l’homme et pour l’environnement.
Le mécanisme d’action des bactériophages
Les bactériophages sont des virus ultraciblés, naturellement présents dans l’environnement, qui parasitent exclusivement les bactéries : une fois injectés, ils s’attachent à leur paroi, injectent leur ADN viral puis répliquent leur matériel génétique à l’intérieur de la cellule hôte. En quelques heures, la bactérie se rompt, libérant de nouveaux phages prêts à infecter d’autres micro-organismes indésirables. Cette boucle autoréplicative garantit une couverture étendue et un effet auto-entretenu tant que des bactéries cibles sont présentes.
En utilisant un cocktail de phages, on élargit la cible aux souches d’E. coli et de Salmonella les plus courantes, réduisant significativement le risque de développement de résistances croisées.
Des résultats expérimentaux prometteurs
Dans les essais rapportés dans *Science Advances*, les patchs micro-aiguilles ont été testés sur deux scénarios pratiques :
Ces performances dépassent largement celles des traitements de surface classiques et ouvrent la voie à une approche plus sûre et plus respectueuse de la chaîne alimentaire.
Avantages et bénéfices pour la filière
L’utilisation de ces patchs bactériophages présente plusieurs atouts :
Les défis à venir et perspectives d’adoption
Avant de voir ces innovations débarquer massivement sur les lignes de production ou dans les rayons de supermarchés, plusieurs étapes sont à franchir :
Si ces étapes se concluent positivement, les cerotti bactériophages pourraient devenir un outil de référence pour réduire drastiquement les intoxications alimentaires et ralentir la progression de l’antibiorésistance.
Un futur sans antibiotiques ?
La réussite de ces patchs, fruit de la recherche fondamentale et des innovations biomédicales, illustre la puissance des bactériophages comme alternative aux antibiotiques. À terme, ils pourraient transformer la gestion de la sécurité alimentaire et offrir aux consommateurs une garantie supplémentaire de fraîcheur et d’innocuité. Cette technologie, si elle est adoptée à grande échelle, contribuera à préserver l’efficacité des traitements antibiotiques pour les cas où ils restent indispensables.